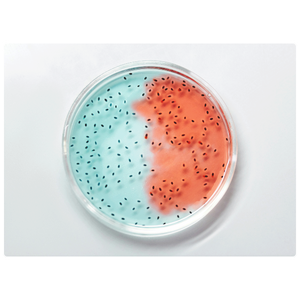
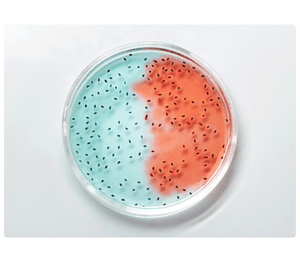

Tratamientos
especiales
Los Tratamientos Especiales están diseñados para abordar necesidades únicas y situaciones particulares que requieren un acompañamiento energético más profundo y personalizado. Con el apoyo de la tecnología cuántica, se trabajan frecuencias específicas para equilibrar tu campo energético de manera integral y adaptada a cada caso.
Este enfoque brinda un espacio seguro y sensible, donde la armonización se ajusta a tu momento vital y a los retos que enfrentas, favoreciendo una transformación completa en cuerpo, mente y espíritu.
Atender desequilibrios energéticos complejos o persistentes.
Recibir apoyo personalizado en procesos de cambio o recuperación.
Armonizar planos físicos, emocionales y espirituales de forma integrada.
Potenciar la energía vital, facilitando un estado de bienestar renovado.
Una experiencia única, creada a tu medida, que conecta la innovación cuántica con la sensibilidad de lo holístico para acompañarte en tu camino de sanación.